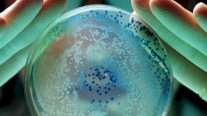
تحذير صحي خطير.. أداة يستخدمها ملايين الأشخاص أكثر قذارة 40 مرة من مقعد المرحاض

إيلاف من واشنطن: كشفت دراسة حديثة أجراها باحثون في جامعة واشنطن بمدينة سانت لويس، ونشرت نتائجها في دورية Annals of Neurology، عن تأثير محتمل لأدوية النوم على البروتينات المرتبطة بمرض ألزهايمر، مما يفتح آفاقًا جديدة لفهم العلاقة بين النوم وصحة الدماغ.
الدراسة ركزت على دواء الأرق الشائع "سوفوريكسانت" (suvorexant)، والذي أظهر انخفاضًا ملحوظًا في مستويات بروتين الأميلويد بيتا بنسبة تتراوح بين 10% إلى 20%، وكذلك انخفاضًا مؤقتًا في بروتين تاو المفسفر، أحد العلامات الحيوية المرتبطة بتطور مرض ألزهايمر.
قاد الدراسة الدكتور بريندان لوسي، مدير مركز طب النوم بجامعة واشنطن، وشارك فيها 38 متطوعًا من الأصحاء تتراوح أعمارهم بين 45 و65 عامًا، لا يعانون من أي مشكلات إدراكية أو اضطرابات نوم. خلال تجربة استغرقت 36 ساعة، تلقى المشاركون إما جرعات مختلفة من سوفوريكسانت أو دواء وهمي، وجُمعت عينات من السائل النخاعي كل ساعتين لرصد التغيرات الكيميائية.
ورغم النتائج المشجعة، شدد الدكتور لوسي على ضرورة توخي الحذر، مؤكدًا أن التجربة قصيرة المدى ولم تشمل مرضى ألزهايمر أو حتى أصحاب اضطرابات النوم، ما يجعل من المبكر للغاية التوصية باستخدام مثل هذه الأدوية لأغراض وقائية.
كما أشار الباحثون إلى وجود مخاوف بشأن الآثار الجانبية المحتملة للاستخدام المطوّل لأدوية النوم، بما في ذلك خطر الإدمان وتأثيرها على النوم العميق، وهو عنصر أساسي في التخلص من الفضلات السامة في الدماغ.
تأتي هذه النتائج وسط جدل علمي متزايد حول فعالية العقاقير التي تستهدف لويحات الأميلويد، خاصة بعد إخفاق العديد منها في إيقاف أو عكس تقدم مرض ألزهايمر. ومع ذلك، تبقى اضطرابات النوم مؤشرًا واعدًا في الكشف المبكر عن المرض، حيث تشير دراسات سابقة إلى أن مشكلات النوم قد تسبق ظهور الأعراض الإدراكية بسنوات.
وفي هذا السياق، يدعو الخبراء إلى التركيز على استراتيجيات أكثر أمانًا لتعزيز صحة الدماغ، مثل تحسين "نظافة النوم" وعلاج الاضطرابات الكامنة مثل انقطاع النفس النومي، بدلًا من الاعتماد على الأدوية المنومة.
ويختم الدكتور لوسي بالتأكيد على أن هذه النتائج تمثل "خطوة مهمة في طريق طويل لفهم الآليات المعقدة للمرض"، لكنها ليست نهاية المطاف، بل بداية لسلسلة من الأبحاث الضرورية لتطوير علاجات فعالة تستهدف الصلة بين النوم والدماغ.

التعليقات